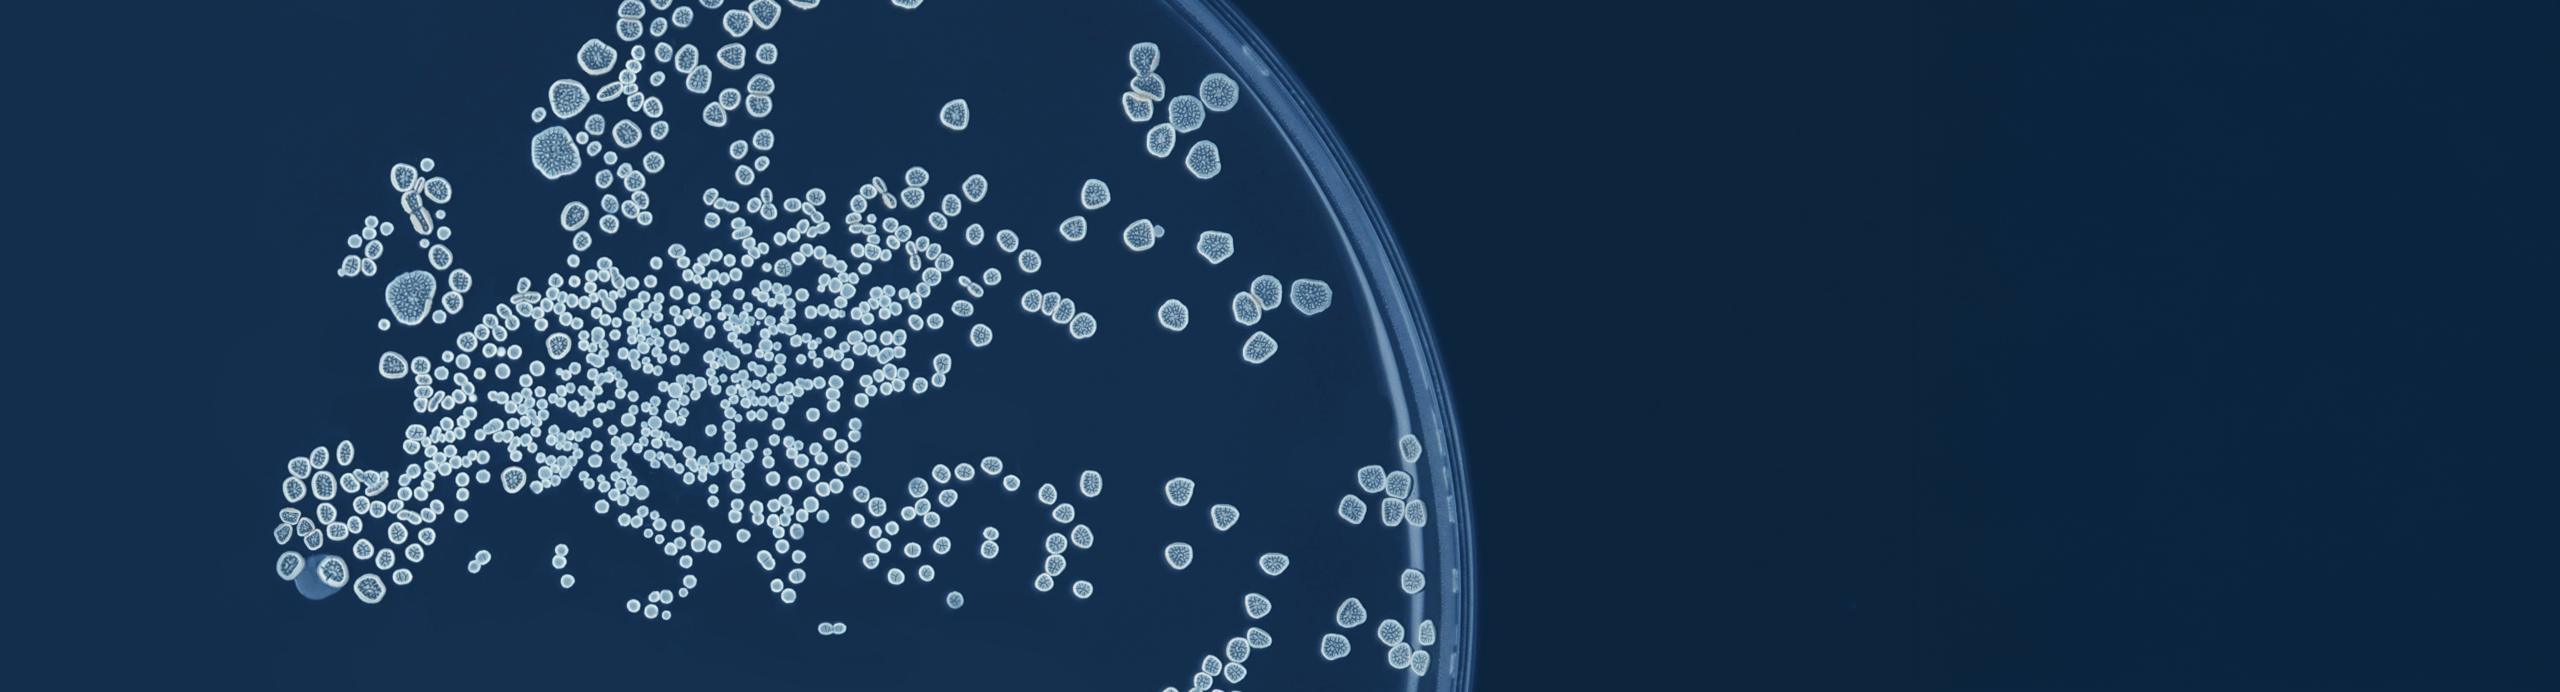
bg-overlay

The European Academy of Microbiology (EAM) is pleased to announce the election of 95 new Fellows, recognising scientific excellence and long-standing contributions to microbiology.
The newly elected Fellows represent a diverse range of expertise across microbiology and related disciplines, spanning institutions across Europe and beyond. Their work reflects the breadth and dynamism of the field, from fundamental microbial research to applied innovations addressing global challenges in health, environment, and biotechnology.
Election to the EAM Fellowship recognises outstanding scientific achievement and leadership in microbiology. Fellows are selected through a rigorous nomination and evaluation process by existing members of the Academy.
With the addition of these new Fellows in different areas of microbiology from Europe and beyond, the EAM continues to strengthen its network of leading microbiologists. As Fellows of the Academy, members are committed to advancing knowledge, fostering collaboration, and supporting the next generation of scientists. Together they promote the visibility, impact and rapid progress of microbiology across the world.
Reflecting strength and diversity of microbiology
Commenting on the election, the EAM President Prof. Cecília M. Arraiano said:
“We are delighted to welcome this new group of Fellows to the European Academy of Microbiology. Their achievements and expertise reflect the strength and diversity of microbiology. The Academy thrives through the engagement of its Fellows, and we look forward to the perspectives and contributions they will bring to shape the future of microbial science.”
See the full list of the newly elected Fellows.
About the European Academy of Microbiology (EAM)
The European Academy of Microbiology, is part of the Federation of European Microbiological Societies (FEMS) network, and brings together eminent microbiologists whose work has significantly advanced the field. Through the collective expertise of its Fellows, the Academy contributes to scientific dialogue, supports emerging priorities in microbiology, and helps amplify the impact of microbiological research for society.